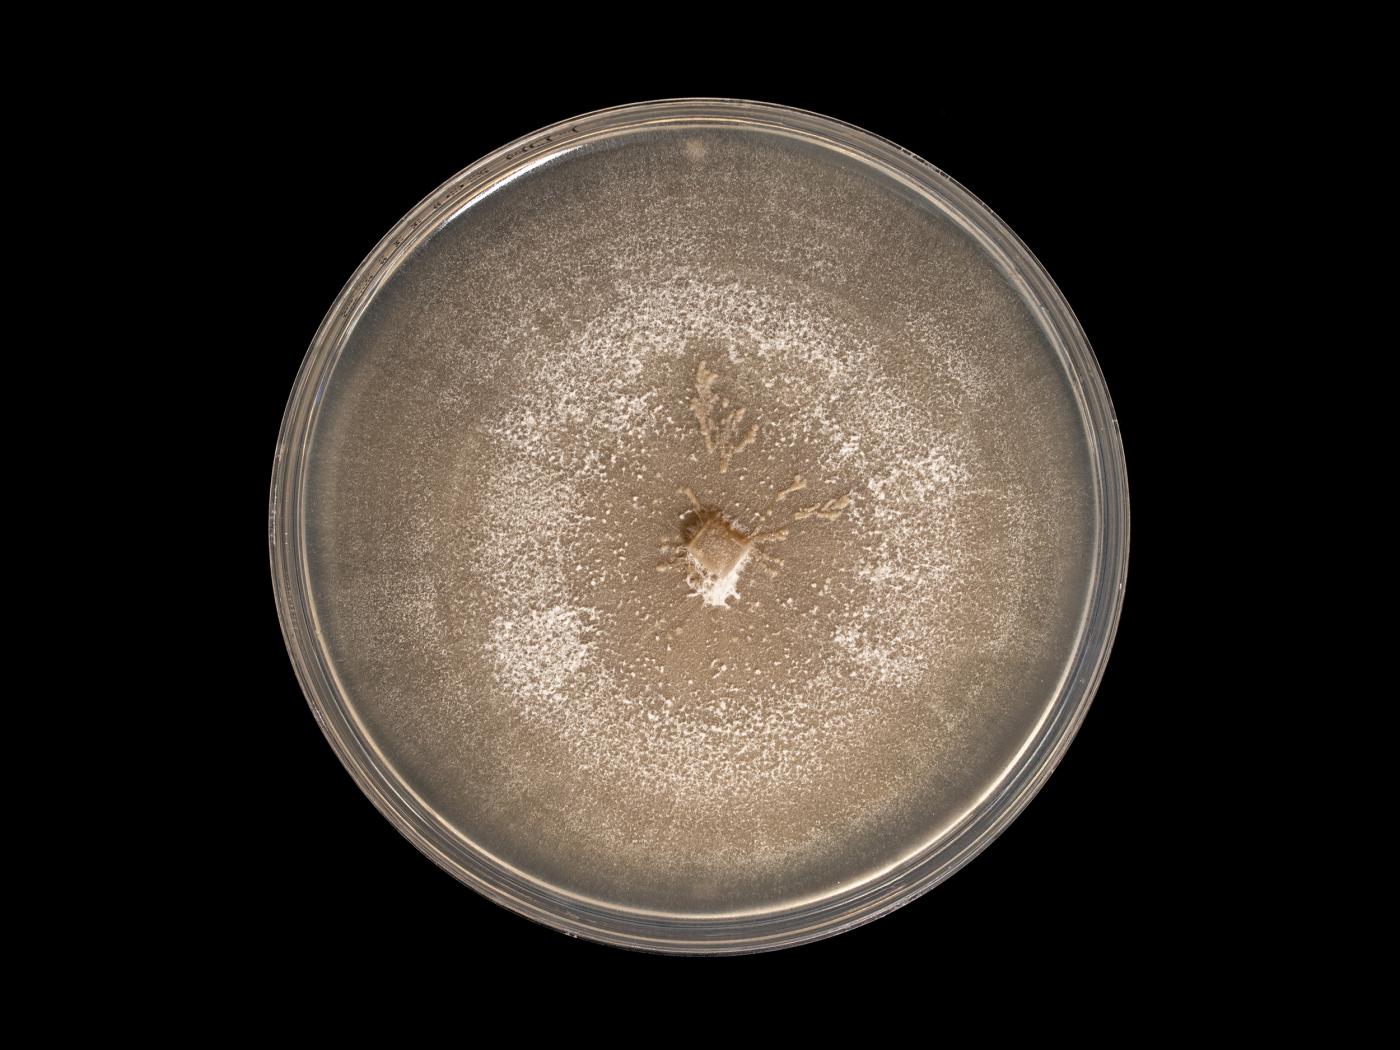

Nom latin :
Plectosphaerella cucumerina
Nom latin synonyme :
Plectosporium tabacinum, Microdochium tabacinum
Dommages
Le champignon Plectosphaerella cucumerina peut affecter les cultures suivantes : courges, citrouille, cucurbitacées, potiron et tomate.
Cultures ou autres organismes affectés
Citrouille
/fr/maladies-parasitaires/champignons/plectosphaerella-cucumerina/citrouille-tache-plectosporienne
Citrouille - Tache plectosporienne (Plectosporium sp.)_1
Citrouille - Tache plectosporienne (Plectosporium sp.)_2
Citrouille - Tache plectosporienne (Plectosporium sp.)_2
Courges
/fr/maladies-parasitaires/champignons/plectosphaerella-cucumerina/courges-tache-plectosporienne
Courges - Tache plectosporienne (Plectosphaerella cucumerina)_1
Courges - Tache plectosporienne (Plectosphaerella cucumerina)_2
Courges - Tache plectosporienne (Plectosphaerella cucumerina)_3
Courges - Tache plectosporienne (Plectosphaerella cucumerina)_4
Courges - Tache plectosporienne (Plectosphaerella cucumerina)_2
Courges - Tache plectosporienne (Plectosphaerella cucumerina)_3
Courges - Tache plectosporienne (Plectosphaerella cucumerina)_4
Tomate
/fr/maladies-parasitaires/champignons/plectosphaerella-cucumerina/tomate-chancre-sec-plectosphaerella
Tomate - Chancre sec (Plectosphaerella cucumerina)_1
Tomate - Chancre sec (Plectosphaerella cucumerina)_2
Tomate - Chancre sec (Plectosphaerella cucumerina)_3
Tomate - Chancre sec (Plectosphaerella cucumerina)_4
Tomate - Chancre sec (Plectosphaerella cucumerina)_2
Tomate - Chancre sec (Plectosphaerella cucumerina)_3
Tomate - Chancre sec (Plectosphaerella cucumerina)_4